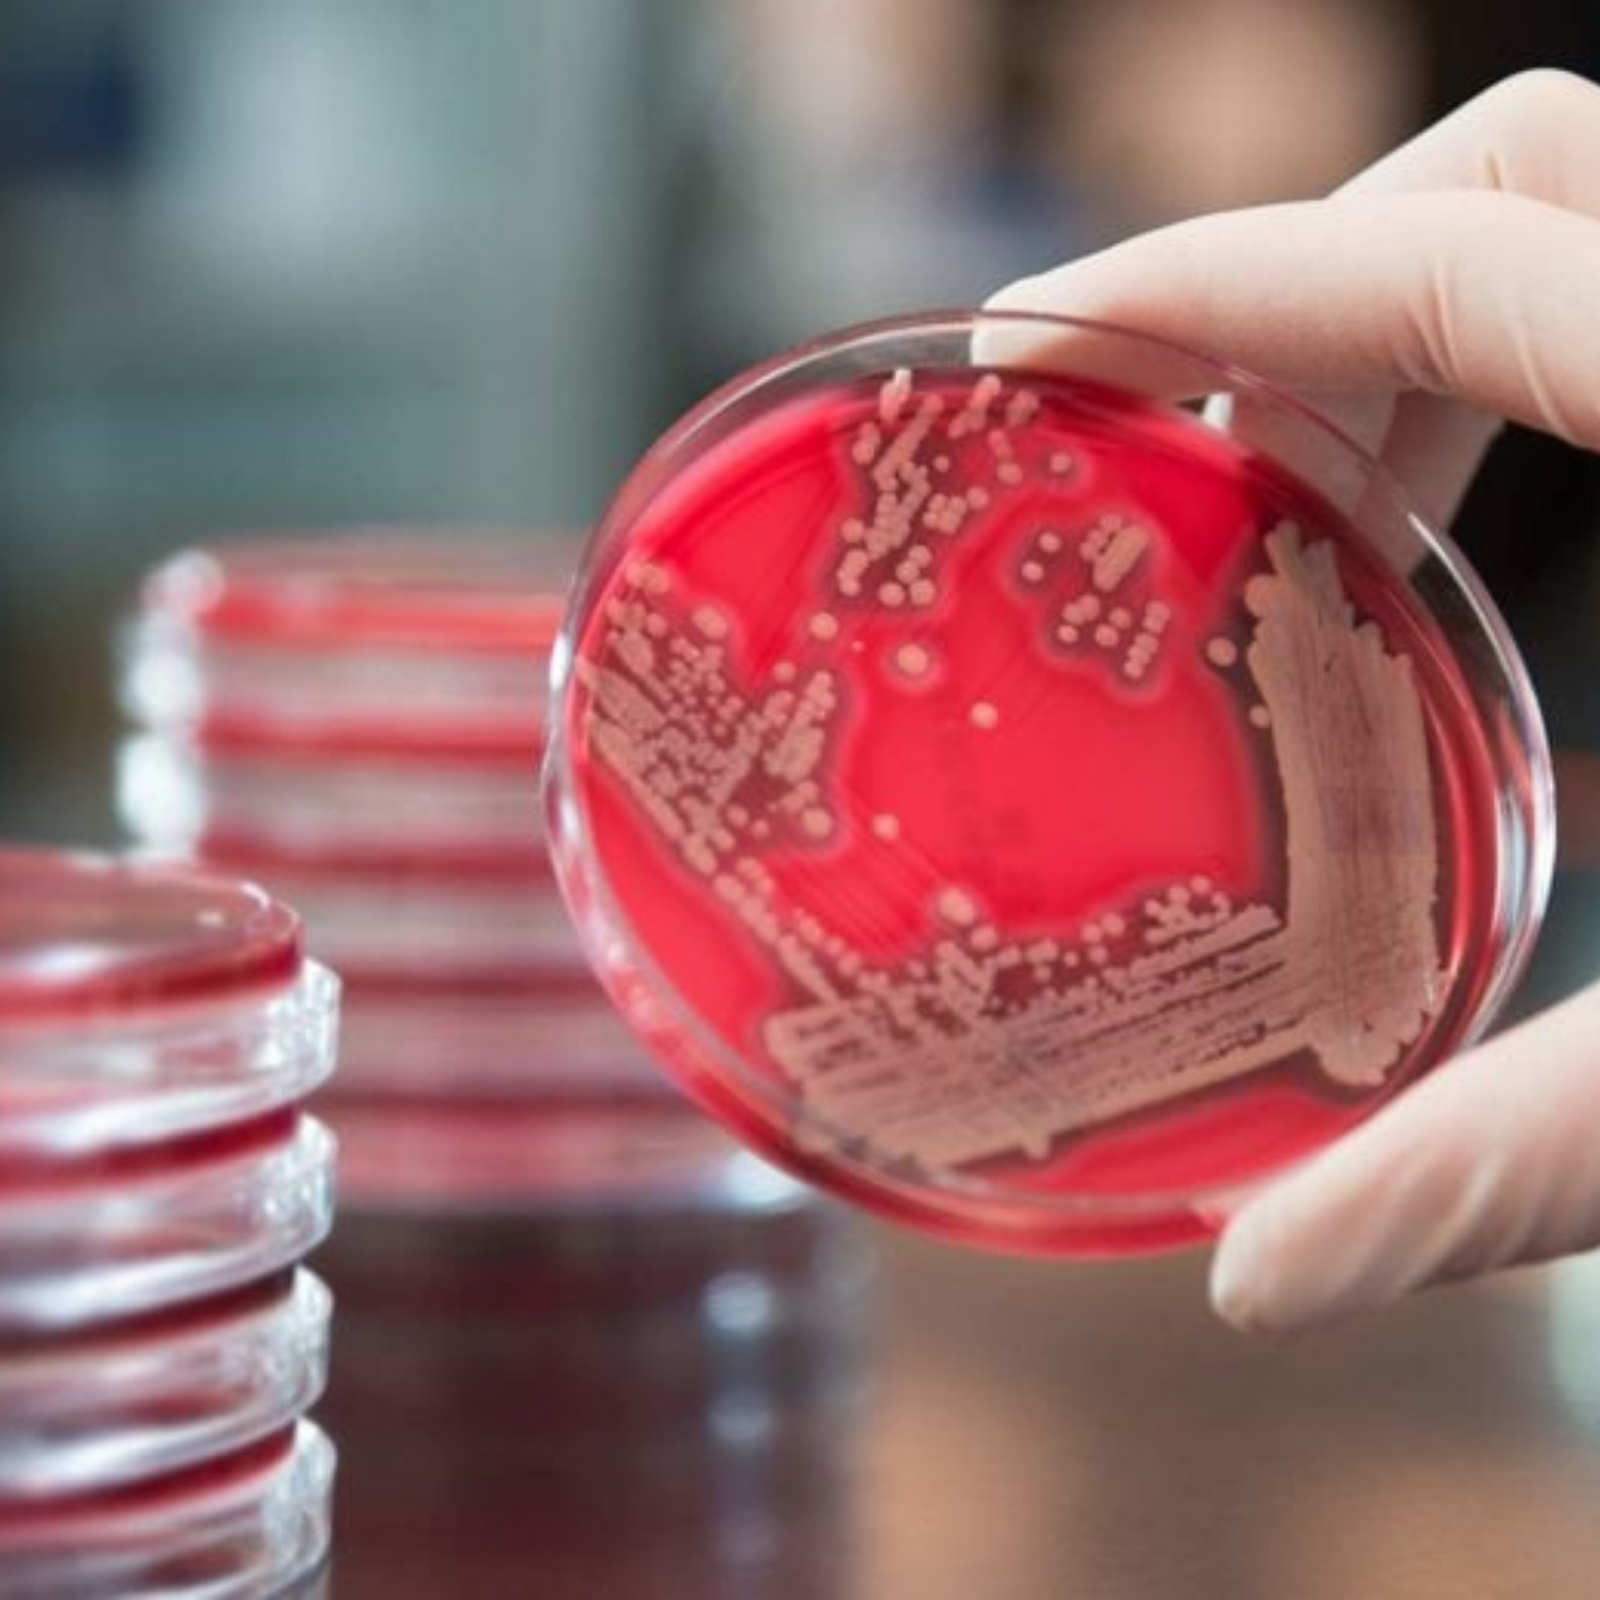

Millions of medical devices are surgically used or implanted in patients globally every year. Despite our best efforts to prevent contamination, medical device-related infections are on the rise.
With the emergence of antibiotic-resistant bacteria, the clinical unmet need for improved methods of reducing medical device contamination has never been more important.
We believe the estimated 1-5% average rate of medical device-related infections for primary and revisionary surgeries is too conservative. With surgeries on the rise and improved detection methods for occult infection becoming more readily available, a more accurate estimated overall device infection rate could be as high as 5-15%.
A number of studies performed in the past decade that have analyzed failed orthopedic devices that were removed due to aseptic loosening revealed device contamination rates in the range of 38-100%, suggesting that the prevalence of occult device-related infection could be far greater than we initially believed.
With the emergence of antibiotic-resistant bacteria, the increasing use of immunosuppressant agents, and an ever greater number of revision surgeries being performed, the clinical unmet need for improved methods of reducing medical device contamination has never been greater.
In order to better comprehend how Orthobond’s platform technology works, it is helpful to first understand the dynamics that cause medical devices to become infected in the first place.
Most devices will see a bacterial challenge at some point. Devices are magnets for bacterial attachment; roughly 100 to 10,000 times fewer bacteria are required to cause an infection in the body when a foreign body, such as a medical device, is present (Moriarty et al., 2014)
When a medical device is implanted, a ‘race to the surface’ begins, in which normal host cells and floating bacteria compete for adhesion with the device.
When normal host cells win the race, bacteria are unable to attach, and normal tissue integration occurs. However, when bacteria attach to the surface of the device first and are able to multiply and mature, a negative loop forms—frequently culminating in the formation of biofilm on the surface of the device. Biofilm renders bacteria less susceptible to antibiotics and often marks the beginning of the end for the device.
When a medical device becomes infected, a patient may first experience minor symptoms, such as pain and swelling, which can worsen overtime. Often, the patient is given a heavy course of antibiotics—sometimes for the duration of their lifetime—which may or may not be effective in treating the infection.
Sometimes, revision surgery is necessary to address the infection, and the patient must undergo a repeat surgical operation to remove the device. Revision surgery is not without risk and, in extreme cases, can involve amputation. In about 0.4-2% of cases, the patient dies as a result of the infected device.
Many attempts have been made to address the ongoing problem of implant contamination, most often by either improving sanitary practices before, during, and after surgical operations, or by engineering medical device surfaces to kill bacteria upon contact. On the whole, these attempts have not been very successful.
Orthobond’s technology is unlike anything that is currently on the market.
Our team has been working for over a decade to improve patient outcomes by developing technologies that aim to significantly reduce bacterial contamination during surgeries involving medical devices and instruments.
In the process, we’ve tested over one thousand different linker-agent combinations to come up with what we believe is the best solution.
Our surface treatments are non-eluting and non-antibiotic, and are thus highly unlikely to create drug-resistant bacteria. In addition, Orthobond’s technology is supported by a substantial suite of biocompatibility and safety data and utilizes a molecule that has a history of safe use in humans.
Orthobond’s technology makes use of powerful covalent linker technology that presents a highly efficacious antimicrobial with broad-spectrum activity directly on the device surface.
Our nanosurface treatments have been shown to be effective against the majority of microorganisms that are typically associated with device infections, including S. aureus, MRSA, S. epidermidis, P. acnes, P. aeruginosa, E. coli, and C. albicans.
Our surface treatments are broadly-patented and can be easily applied to a wide variety of biomaterials commonly used in medical devices, instruments, and ancillary components via a simple, scalable, and cost-effective manufacturing process.